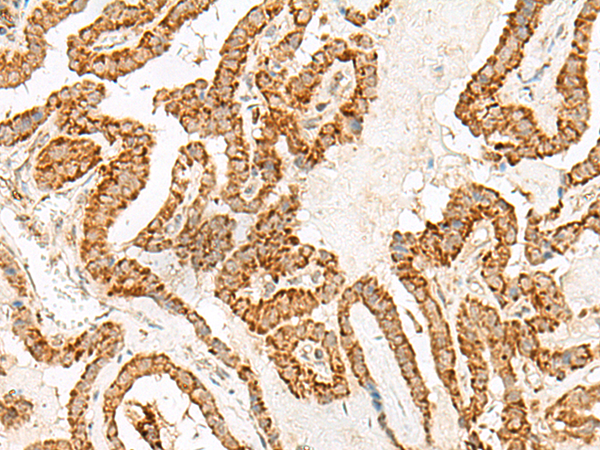
一抗

中文名稱 : 兔抗NUP210多克隆抗體
英文名稱 : Anti-NUP210 rabbit polyclonal antibody
別 名 : nucleoporin 210; GP210; POM210
儲 存 : 冷凍(-20℃)
抗 原 : NUP210
宿 主 : Rabbit
反應種屬 : Human, Mouse, Rat
相關類別 : 一抗
標 記 物 : Unconjugate
克隆類型 : rabbit polyclonal
技術規(guī)格
|
Background: |
The nuclear pore complex is a massive structure that extends across the nuclear envelope, forming a gateway that regulates the flow of macromolecules between the nucleus and the cytoplasm. Nucleoporins are the main components of the nuclear pore complex in eukaryotic cells. The protein encoded by this gene is a membrane-spanning glycoprotein that is a major component of the nuclear pore complex. Multiple pseudogenes related to this gene are located on chromosome 3. |
|
Applications: |
ELISA, IHC |
|
Name of antibody: |
NUP210 |
|
Immunogen: |
Synthetic peptide of human NUP210 |
|
Full name: |
nucleoporin 210 |
|
Synonyms: |
GP210; POM210 |
|
SwissProt: |
Q8TEM1 |
|
ELISA Recommended dilution: |
5000-10000 |
|
IHC positive control: |
Human ovarian cancer and Human thyroid cancer |
|
IHC Recommend dilution: |
30-150 |


 購物車
購物車 幫助
幫助
 021-54845833/15800441009
021-54845833/15800441009